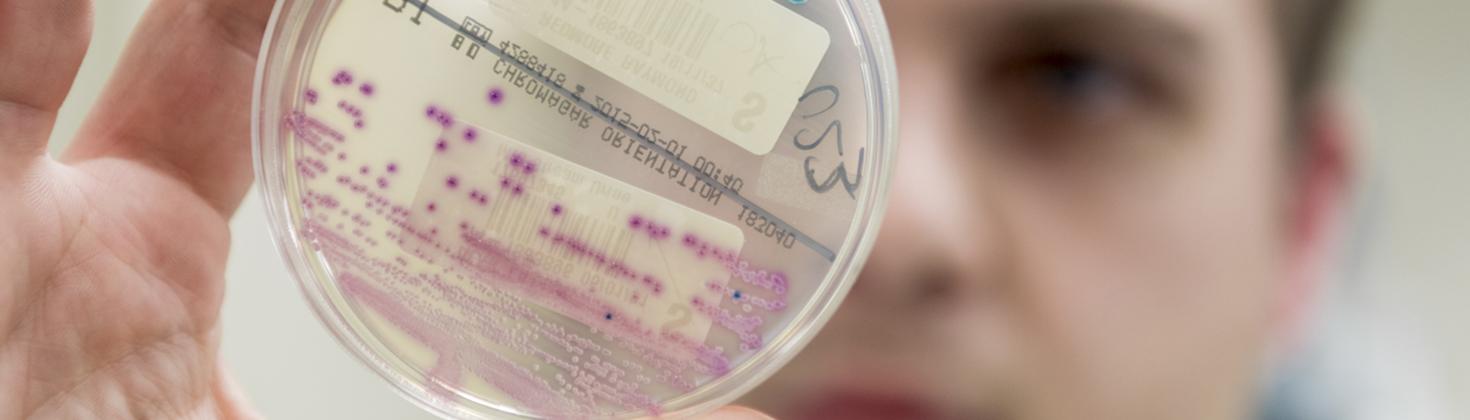

Immunology research taking place at North Bristol NHS Trust
Please speak to the person treating you to see if there is a research study that may be able to help you.
Current Studies:
Hereditary Angioedema (HAE) studies a disorder that results in recurrent attacks of severe swelling.
Please speak to the person treating you to see if you can take part in our current research studies listed below.
Oasis - IONIS CS7
A phase 3 double blind, placebo-controlled study to evaluate the efficacy and safety of prophylactic Donidalorsen in HAE. Patient recruitment is closed but current and new participants may enrol to an open-label extension study. Patients need to have at least 2 HAE attacks within the last 2 consecutive months to participate. There are also other inclusion /exclusion criteria and recruitment is subject to availability.
Project Details
Principal Investigator:
Planned End Date: 31/12/24
Local Ref: 5248
Chapter-1 Pharvaris
Chapter-1 is a phase 2 double-blind, placebo-controlled, randomized, dose-ranging, parallel group study to evaluate the safety and efficacy of PHA-022121 administered orally for prophylaxis against angioedema attacks in patients with HAE. Patients need to have at least 3 HAE attacks within the last 3 consecutive months to participate. There are also other inclusion /exclusion criteria and taking part in the study is subject to availability.
Project Details
Principal Investigator:
Planned End Date: 31/12/2023
Local Ref: 5046
Take Part in Research

Become one of the thousands of people taking part in research every day within the NHS.
About Research & Development

Find out more about our research and how we're working to improve patient care.
Contact Research
Research & Development
North Bristol NHS Trust
Level 3, Learning & Research building
Southmead Hospital
Westbury-on-Trym
Bristol, BS10 5NB
Telephone: 0117 4149330
Email: research@nbt.nhs.uk